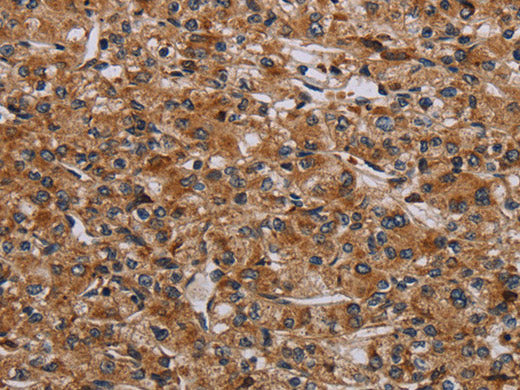
p70 S6 kinase beta Polyclonal Antibody

p70 S6 kinase beta Polyclonal Antibody
Regular price
$ 559.95
Couldn't load pickup availability

Still have questions? Ask our experts!
p70 S6 kinase beta Polyclonal Antibody
| SKU # | E-AB-13487 |
| Reactivity | Human, Mouse |
| Host | Rabbit |
| Applications | IHC |
Product Details
| Isotype | IgG |
| Host | Rabbit |
| Reactivity | Human, Mouse |
| Applications | IHC |
| Clonality | Polyclonal |
| Immunogen | Synthetic peptide of human RPS6KB2 |
| Abbre | p70 S6 kinase beta |
| Synonyms | 70 kDa ribosomal protein S6 kinase 2, EC 2.7.11.1, KS6B2, P70S6K2, Ribosomal pr, Ribosomal protein S6 kinase 70kDa, p70 S6 kinase beta, p70 S6K-beta, p70 S6KB, p70 S6Kbeta, p70 beta, p70 ribosomal S6 kinase beta, p70(S6K) beta, p70-S6K 2, p70-beta, p70S6Kb, polypeptide 2 |
| Swissprot | |
| Cellular Localization | Nucleus, nucleoplasm, nucleus, Other locations: cytoplasm. |
| Concentration | 0.4 mg/mL |
| Buffer | Phosphate buffered solution, pH 7.4, containing 0.05% stabilizer and 50% glycerol. |
| Purification Method | Affinity purification |
| Research Areas | Cancer, Metabolism, Signal Transduction |
| Conjugation | Unconjugated |
| Storage | Store at -20°C Valid for 12 months. Avoid freeze / thaw cycles. |
| Shipping | The product is shipped with ice pack, upon receipt, store it immediately at the temperature recommended. |
Related Reagents
| Applications | Recommended Dilution |
| IHC | 1:50-1:200 |
Background
This gene encodes a member of the RSK (ribosomal S6 kinase) family of serine/threonine kinases. This kinase contains 2 nonidentical kinase catalytic domains and phosphorylates the S6 ribosomal protein and eucaryotic translation initiation factor 4B (eIF4B). Phosphorylation of S6 leads to an increase in protein synthesis and cell proliferation.